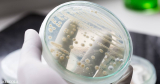

- Show all
- Hottest
- Popular
The search for anti-aging products is probably one of the most elusive yet expensive pursuits. Statistics indicate that the global anti-aging market size ...
Analysis by Dr. Joseph Mercola February 07, 2024Download PDF 74488
Winter is here, and with the colder temperatures making its way in, many people will be looking for ways to stay warm and healthy during this season. ...
Analysis by Dr. Joseph Mercola February 07, 2024Download PDF 244556
With the growing popularity of natural and alternative methods for achieving health and wellness, it’s no surprise that people are turning to psychedelics ...
After the COVID vaccines came out, we began to encounter more and more patients who had a compelling case history that suggested that were being repeatedly ...
Magic mushrooms have been gaining popularity in recent years for their perceived ability to induce profound psychedelic experiences and open the mind to ...
Analysis by Dr. Joseph Mercola February 06, 2024Download PDF 128324
Are you in search of high-quality Bliss CBD Formula Australia? With the growing popularity of Cannabidiol products, it's no surprise that consumers are ...
Analysis by Dr. Joseph Mercola February 06, 2024Download PDF 20293
Slip and fall accidents can happen anywhere, anytime, to anyone. Accidents can result in serious injuries and may have long-term consequences. Such ...
Analysis by Dr. Joseph Mercola February 06, 2024Download PDF 258271